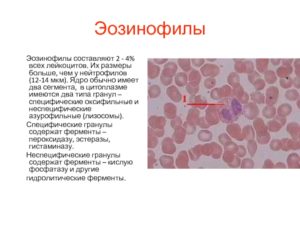
image

Эозинофилы в крови повышены, какая норма, причины увеличения результата анализа у детей, взрослых
Обновление: Октябрь 2018
Среди множества клеток крови существует популяция лейкоцитов, называемых эозинофилами, которые являются маркерами, определяющими:
- аллергию
- инфекционные
- паразитарные агрессий
- повреждения тканей воспалением
- или опухолью.
Свое название клетки получили за счет способности отлично впитывать краситель эозин, используемый в лабораторной диагностике.
Под микроскопом клетки похожи на маленьких амеб с двойным ядром, которые способны двигаться за пределы сосудистой стенки, проникать в ткани и накапливаться в воспалительных очагах или местах повреждения ткани. В крови эозинофилы плавают около часа, после чего транспортируются в ткани.
Главные свойства эозинофилов:
- Повышение чувствительности рецепторов к иммуноглобулинам класса Е. За счет этого активизируется противопаразитарный иммунитет, и происходит разрушение мембран клеток, окружающих паразита. Капсула из обломков мембран становится маяком для клеток, которые инактивируют или пожирают паразита.
- Накопление и стимуляция высвобождения медиаторов воспаления.
- Поглощение и связывание медиаторов воспаления, прежде всего, гистамина
- Способность поглощать мелкие частицы, обволакивая их своей стенкой и втягивая их в себя. За это эозинофилы называют микрофагами.
Норма эозинофилов в крови 1 — 5
Для взрослых нормальным содержанием эозинофилов в клиническом анализе крови считается от 1 до 5% от общего числа лейкоцитов. Эозинофилы определяются методом проточной цитометрии с использование полупроводникового лазера, при этом норма у женщин такая же, как и у мужчин. Более редкие единицы измерения – число клеток в 1 мл крови. Эозинофилов должно быть от 120 до 350 в миллилитре крови.
Число этих клеток может колебаться в течение суток на фоне изменения работы надпочечников.
- В утренние вечерние часы эозинофилов на 15% больше по сравнению с нормой
- В первую половину ночи на 30% больше.
Для более достоверного результата анализа следует:
- Сдавать анализ крови в ранние утренние часы натощак.
- За два дня следует воздерживаться от алкоголя и чрезмерного употребления сладостей.
- Также эозинофилы могут повышаться во время менструаций у женщин. Начиная с момента овуляции, до конца цикла их число падает. На этом феномене основан эозинофильный тест работы яичников и определения дня овуляции. Эстрогены увеличивают созревание эозинофилов, прогестерон – снижает.
Эозинофилы: норма у детей
По мере роста ребенка число эозинофилов в его крови колеблется несильно, что видно из таблицы.
| Возраст | Эозинофилы в % |
| Первые 2 недели | 1-6 |
| 15 суток — год | 1-5 |
| 1,5-2 года | 1-7 |
| 2 года-5 лет | 1-6 |
| старше 5 лет | 1-5 |
Эозинофилы выше нормы, что это значит
Значимым повышением количества эозинофилов считается состояние, когда клеток более 700 в миллилитре (7 на 10 в 9 грамм на литр). Повышенное содержание эозинофилов носит наименование эозинофилии.
- Рост до 10% — легкая степень
- От 10 до 15% — умеренная
- Свыше 15% (больше 1500 клеток в миллилитре) – выраженная или тяжелая эозинофилия. При этом могут наблюдаться изменения во внутренних органов за счет клеточного и тканевого кислородного голодания.
Иногда при подсчете клеток возникают ошибки. Эозином прокрашиваются не только эозинофильные гранулоциты, но и зернистость в нейтрофилах, тогда нейтрофилы понижены, а эозинофилы повышены без веских к тому причин. В таком случае потребуется контрольный анализ крови.
Что ведет к эозинофилии
Когда в крови повышены эозинофилы, причины кроются в аллергической готовности организма. Это происходит при:
- острых аллергических состояниях (отеке Квинке, крапивнице, сенной лихорадке)
- аллергии на лекарства, сывороточной болезни
- аллергическом рините
- кожных аллергиях (контактном дерматите, экземе, атопическом дерматите, вульгарной пузырчатке)
- гельминтозах (см. признаки глистов у человека)
- паразитарных болезнях (токсоплазмозе, хламидиозе, амебиазе)
- острых инфекциях и обострениях хронических (туберкулезе, гонорее, инфекционном мононуклеозе)
- системных патологиях (системной красной волчанке, эозинофильном фасциите, ревматоидном артрите, периартериите узелковом)
- патологии легких: бронхиальной астме, фиброзирующем альвеолите, саркоидозе, эозинофильном плеврите, гистиоцитозе, болезни Лефлера
- поражениях желудочно-кишечного тракта: эозинофильном гастрите, эозинофильном колите
- опухолях крови (лимфогранулематозе, лимфомах)
- злокачественных новообразованиях.
Если в анализе повышены эозинофилы, у взрослого собирается:
Далее назначается консультация аллерголога:
- При аллергическом рините берутся мазки из носа и зева на эозинофилы.
- При подозрении на бронхиальную астму выполняется спирометрия и провокационные пробы (холодовая, с беротеком).
- Аллерголог в дальнейшем проводит специфическую диагностику (определение аллергенов по стандартным сывороткам), уточняет диагноз и назначает лечение (антигистамины, гормональные препараты, сыворотки).
От глистной инвазии, паразитарных болезней и острых инфекций лечит инфекционист. Легочными проблемами займется пульмонолог.
Эозинофилы повышены у ребенка
Наиболее частыми причинами повышенных эозинофилов у детей становятся:
Эозинофилы ниже нормы
Если абсолютное число эозинофилов в миллилитре крови падает ниже 200, состояние интерпретируется, как эозинопения.
Низкими показатели эозинофилов становятся в следующих случаях:
- При тяжелых гнойных инфекциях, в том числе, сепсисе, когда популяция лейкоцитов сдвигается в сторону юных форм (палочкоядерных и сегментоядерных), а затем лейкоцитарный ответ истощается.
- В начале воспалительных процессов, при хирургических патологиях (аппендиците, панкреатите, обострении желчнокаменной болезни).
- В первые сутки инфаркта миокарда.
- При инфекционном, болевом шоке, когда форменные элементы крови склеиваются в тиноподобные образования внутри сосудов.
- При отравлениях тяжелыми металлами (свинцом, медью, ртутью, мышьяком, висмутом, кадмием, таллием).
- При хроническом стрессе.
- На фоне патологий щитовидной железы и надпочечников.
- В развернутую стадию лейкоза эозинофилы падают до нуля.
Сочетанные повышения эозинофилов
- Лимфоциты и эозинофилы бывают повышены при вирусных инфекциях у аллергиков, у пациентов с аллергодерматозами или гельминтозами. Такая же картина будет в крови у тех, кто лечится антибиотиками или сульфаниламидами. У детей эти клетки повышаются при скарлатине, наличии вируса Эпштейна-Барра. Для дифференциальной диагностики дополнительно рекомендуется сдать кровь на уровень иммуноглобулинов Е, на антитела к вирусу Эпштейна-Барра и кал на яйца глистов.
- Моноциты и эозинофилы возрастают при инфекционных процессах. Самый типичный случай у детей и взрослых – мононуклеоз. Аналогичная картина может быть при вирусных и грибковых заболеваниях, риккетсиозе, сифилисе, туберкулезе, саркоидозе.
Постнова Мария Борисовна врач-терапевт
Что значат повышенные эозинофилы в анализе крови у взрослых?

Материалы публикуются для ознакомления, и не являются предписанием к лечению! Рекомендуем обратиться к врачу-гематологу в вашем лечебном учреждении!
Соавторы: Марковец Наталья Викторовна, врач-гематолог
Эозинофилами называют разновидность лейкоцитов, окрашивающихся кислым пигментом эозином.
Что такое эозинофилы в анализе крови и какую функцию они выполняют? Это сегментоядерные образования, способные просачиваться сквозь стенки кровеносных сосудов и передвигаться внутри тканей, направляясь к очагу воспаления, травмы или внедрения чужеродного агента. Повышение их уровня в анализе крови — тревожный сигнал.
- Эозинофилия и её причины
- Показания к сдаче крови
- Методы лечения
Эозинофилы повышены, когда организм атакуют паразиты и при развитии аллергических состояний. Эозинофилы образуются в костном мозге в ответ на попадание в организм чуждого белка. Врач узнаёт, что у пациента эозинофилы в крови повышены, при интерпретации результатов стандартного анализа крови.
Эозинофилия и её причины
Важно! Повышением эозинофилов считают уровень 7% от общего числа белых клеток. Различают лёгкую форму, при которой анализы показывают до 10%. Средней формой считают 10-15%, а всё, что выше относят к тяжёлой.
Когда эозинофилы выше нормы, что это значит? Определённо — протекание в организме патологического процесса.
Эозинофилы в крови
Причины повышения эозинофилов у взрослого связаны со следующими факторами:
- Аллергия. Является клиническим симптомом бронхиальной астмы и ряда дерматитов.
- Инвазионные патологии — аскаридоз, описторхоз, лямблиоз.
- Инфекционные заболевания и патологии пищеварительной цепи на стадии выздоровления.
- Раковые новообразования, сопровождающиеся разрушением тканей. Эозинофилы реагируют на продукты распада как на чужеродные белки.
- Болезни органов дыхания.
- Инфаркт миокарда.
- Эозинофилы повышены у взрослого и ребёнка, если используются те или иные лекарственные препараты. Антибиотики, салицилаты, сульфаниламиды, йодаты оказывают на организм аллергическое воздействие, что провоцирует эозинофилию.
- Пищевая аллергия. Развивается при употреблении некоторых, нередко сезонных, овощей, ягод, грибов, рыбы и морепродуктов.
- Аллергические состояния при беременности, во время критических дней.
Важно! Употребление цитрусовых перед сдачей крови на стандартный анализ показывает эозинофилию.
Аллергия вызывает повышение эозинофилов
Показания к сдаче крови
Обнаружение повышенных эозинофилов необходимо при постановке дифференциального диагноза по следующим заболеваниям:
- бронхиальная астма;
- заболевания, вызванные паразитами;
- ревматоидный артрит;
- иммунодефицитные состояния;
- онкология кроветворения: лимфома, лейкоз;
- аллергические реакции.
Самым распространённым методом определения содержания эозинофилов считается стандартный анализ крови. Он назначается всем пациентам, проходящим амбулаторное или стационарное лечение при диагностике всех заболеваний. В частном случае вам может понадобиться иммуноферментный анализ крови на паразитов, с помощью которого вы сможете узнать более подробно о паразитах в вашем организме.
| Общий анализ крови (норма) | ||
| Показатель | Взрослые женщины | Взрослые мужчины |
| Гемоглобин | 120–140 г/л | 130–160 г/л |
| Эритроциты | 3,7—4,7×1012 | 4—5,1×1012 |
| Цветовой показатель | 0,85–1,15 | 0,85–1,15 |
| Регакулоциты | 0,2–1,2% | 0,2–1,2% |
| Тромбоциты | 180—320×109 | 180—320×109 |
| соэ | 2–15 мм/ч | 1–10 мм/ч |
| Лейкоциты | 4—9хЮ9 | 4—9×109 |
| Палочкоядерные | 1–6% | 1–6% |
| Сегментоядерные | 47–72% | 47–72% |
| Эозинофилы | 0–5% | 0–5% |
| Базофилы | 0–1% | 0–1% |
| Лимфоциты | 18-40% | 18-40% |
| Моноциты | 2–9% | 2–9% |
Таблица нормы общего анализа крови
Важно! Сдавать кровь на анализ нужно утром натощак. В течение двух суток до обследования воздерживаются от сладостей, цитрусовых и спиртного.
Эозинофильный катионный протеин (ECP, или ЭКБ) — составная часть гранул эозинофилов. Белки эозинофильных гранул, ликвидирующие паразитов, попутно повреждают ткани, ослабленные аллергическими проявлениями бронхиальной астмы и прочих недугов воспалительного характера.
Высокие эозинофилы взаимосвязаны с зарождением бронхиальной астмы, атипических дерматитов, поражений глаз аллергического характера. Такие же симптомы наблюдают при патологиях среднего уха, аутоиммунных аномалиях, синдроме перманентной усталости, инфекциях и инвазиях различной этиологии.
ECP обладает высокой токсичностью не только для паразитов. Он поражает нервные клетки, эпителий и миокард. Определение уровня ЭКБ считается объективным тестом, подтверждающим причастность эозинофилов к формированию клинических симптомов повышенной чувствительности. По этому тесту можно диагностировать заболевание и мониторить эффективность лечения.
ЭКБ обладает нейротоксичностью, которая усугубляет силу зуда при дерматитах. Установлена положительная корреляция между ростом ЭКБ и интенсивностью кожных аллергий. В процессе выздоровления уровень ЕСР нормализуется.
Зачастую результаты анализов показывают повышенное количество лимфоцитов у взрослых и о возможных причинах данного отклонения можно узнать более подробно в статье на нашем портале.
Анализ крови сдается утром и натощак
Методы лечения
Выполняя защиту организма, эозинофилы, в случае превышения их абсолютного содержания до определённых значений, сами становятся опасными для организма. В местах сосредоточения эозинофилов формируются очаги воспаления и развиваются серьезные заболевания. Возникает вопрос: как понизить число эозинофилов до безопасного уровня?
Лечение эозинофилии — это дело врача-гематолога.
Прежде чем приступать к лечению, гематолог выясняет: почему повышены эозинофилы? Назначаются дополнительные виды диагностики, включающие анализ кала и мочи.
В зависимости от ситуации проводят тесты на функционирование почек и печени, обследование на наличие инвазий, аллергены, соединительнотканные патологии. С особой тщательностью обследуют беременных.
Если поставлен точный диагноз и причину заболевания удаётся ликвидировать, уровень эозинофилов нормализуется синхронно с исчезновением симптомов заболевания.
Рекомендуем изучить похожие материалы:
- 1. Система гемостаза: зачем сдавать анализ на свёртываемость крови
- 2. Как подобрать диету по группе крови: худеем вместе
- 3. Причины и опасности повышения уровня базофилов у детей
- 4. Понизился уровень базофилов у взрослых: как лечить базофилию
- 5. Причины повышения или понижения нейтрофилов в анализе крови у детей?
- 6. Нормы содержания нейтрофилов в крови и какие функции они выполняют
- 7. Правильное питание при повышенном уровне билирубина в крови
Норма эозинофилов в крови, повышенные и пониженные показатели — что это значит

Эозинофилы представляют собой один из видов лейкоцитов, которые постоянно образуются в костном мозге. Они созревают на протяжении 3-4 дней, после чего циркулируют в крови на протяжении нескольких часов и перемещаются в ткани легких, кожи и ЖКТ.
Изменение количества этих клеток называют сдвигом лейкоцитарной формулы, и может свидетельствовать о ряде нарушений в организме. Рассмотрим, что такое эозинофилы в анализах крови, почему они могут быть выше или ниже нормы, какие болезни это показывает и что значит для организма, если они повышены или понижены.
Нормальный уровень у детей и взрослых мужчин и женщин
Основная функция эозинофилов – уничтожение чужеродных белков, которые попадают в организм. Они проникают в очаг патологического процесса, активируют выработку защитных антител, а также связывают и поглощают клетки-паразиты.
Нормы таких частиц в крови определяются общим анализом, и зависят от времени суток, а также возраста пациента. Утром, вечером и ночью их количество может увеличиваться вследствие изменения работы надпочечников.
Из-за физиологических особенностей организма уровень эозинофилов в крови детей может быть выше, чем у взрослых.
| Возраст | Эозинофилы, % |
| 2 недели после рождения | 1-6 |
| 15 дней – год | 1-5 |
| 1,5-2 года | 1-7 |
| 2-5 лет | 1-6 |
| Дети от 5 лет и взрослые | 1-5 |
Что это значит, если показатель повышен
Сдвиг лейкоцитарной формулы с высоким уровнем эозинофилов (эозинофилия) свидетельствует о том, что в организме протекает воспалительный процесс.
В зависимости от степени повышения данного вида клеток эозинофилия бывает легкой (увеличение количества не больше, чем на 10%), умеренной (10-15%) и тяжелой (более 15%).
Тяжелая степень считается достаточно опасным для человека состоянием, так как в этом случае часто отмечаются поражения внутренних органов за счет кислородного голодания тканей.
При диагностике сердечно-сосудистых заболеваний
Само по себе увеличение эозинофилов в крови не может говорить о поражениях сердца или сосудистой системы, но патологии, симптомом которых выступает повышение количества данного вида лейкоцитов, способны стать причиной сердечно-сосудистых заболеваний.
Дело в том, что в месте их скопления со временем формируются воспалительные изменения, разрушающие клетки и ткани. Например, длительные, тяжело протекающие аллергические реакции и бронхиальная астма могут вызвать эозинофильный миокардит – редкое заболевание миокарда, которое развивается вследствие воздействия на него белков эозинофилов.
Основные причины повышения
Превышение эозинофилов может иметь целый ряд разных причин, включая:
- поражение организма паразитами: глистные инвазии, лямблиоз, аскаридоз, токсоплазмоз, хламидиоз;
- острые аллергические реакции и состояния (аллергический ринит, крапивница, отек Квинке, дерматиты разной этиологии);
- легочные заболевания: бронхиальная астма, саркоидоз, плеврит, фиброзирующий альвеолит;
- аутоиммунные патологии, в число которых входят системная красная волчанка, ревматоидный артрит, узелковый периартериит;
- острые инфекционные болезни или обострения хронических (гонорея, туберкулез, инфекционный мононуклеоз);
- онкологические заболевания, в том числе злокачественные опухоли крови – например, лимфогранулематоз;
- прием некоторых медикаментозных препаратов – аспирин, димедрол, папаверин, эуфиллин, сульфаниламиды, противотуберкулезные средства, антибиотики пенициллинового ряда и т.д.
Пониженное содержание в результатах общего анализа
Снижение уровня эозинофилов в крови пациента (эозинопения) представляет собой не менее опасное состояние, чем их повышение. Оно также говорит о наличии в организме инфекции, патологического процесса или поражения тканей, в результате чего защитные клетки устремляются к очагу опасности и их количество в крови резко падает.
О чем говорит при болезнях сердца и сосудов
Наиболее частая причина снижения эозинофилов в крови при заболеваниях сердца – начало острого инфаркта миокарда. В первые сутки количество эозинофилов может снижаться вплоть до их полного исчезновения, после чего по мере регенерации сердечной мышцы, концентрация начинает возрастать.
Чем вызывается понижение
Низкие показатели эозинофилов наблюдаются в следующих случаях:
- тяжелые гнойные инфекции и сепсис – в этом случае лейкоцитарная форму сдвигается в сторону юных форм лейкоцитов;
- на первых стадиях воспалительных процессов и при патологиях, требующих хирургического вмешательства: панкреатит, аппендицит, обострение желчекаменной болезни;
- сильных инфекционных и болевых шоках, вследствие которых происходит склеивание форменных элементов крови в тиноподобные образования, оседающие внутри сосудов;
- нарушения функций щитовидной железы и надпочечников;
- отравления свинцом, ртутью, мышьяком, медью и другими тяжелыми металлами;
- хронические эмоциональные стрессы;
- развернутая стадия лейкозов, когда концентрация эозинофилов может упасть до нуля.
Увеличение количества данного вида лейкоцитов в крови после уменьшения или полного отсутствия является благоприятным прогностическим признаком и говорит о начале выздоровления пациента.
Изменение количества в детском возрасте
Высокие эозинофилы в крови у ребенка — достаточно распространенное явление. У недоношенных детей такое состояние считается вариантом нормы, и при достижении нормальной массы тела исчезает.
В остальных случаях наиболее частыми причинами повышения уровня клеток являются:
- У новорожденных и грудничков на искусственном вскармливании в норме эозинофилы могут быть повышены из-за негативной реакции на коровье молоко, а также ряд лекарственных препаратов. Также эозинофилия у младенцев может быть признаком резус-конфликта, гемолитической болезни, стафилококкового сепсиса или энтероколита, пемфигуса и наследственных заболеваний – например, семейного гистиоцитоза.
- В старшем возрасте количество защитных клеток в крови детей часто увеличивается при атопическом дерматите и пищевой аллергии (часто оно совпадает с введением первого прикорма), а также глистных инвазиях (наличии в организме остриц и аскарид).
- К распространенным причинам этого явления у детей относятся паразитарные заболевания (токсокароз, анкилостомоз), скарлатина, ветряная оспа и эозинофильный гастроэнтерит – заболевание, характерное для пациентов до 20 лет.
Эозинофилы у детей бывают снижены при наличии в организме вирусных или бактериальных инфекций и общем снижении иммунитета. Кроме того, ее могут вызвать длительные физические нагрузки, сильное психоэмоциональное переутомление, а также перенесенные травмы, ожоги или хирургические вмешательства.
В любом случае понижение или повышение уровня эозинофилов в крови является не самостоятельным заболеванием, а симптомом того, что в организме протекает патологический процесс. Чтобы выявить проблему и назначить адекватное лечение, пациенту необходимо пройти комплекс дополнительных исследований и получить консультацию специалиста.
Эозинофилы повышены у ребенка: 10 причин повышения, 7 показаний для анализа

Каждая клеточка нашего организма выполняют свою роль. Сейчас речь пойдёт об эозинофилах.
Что собою представляют эозинофилы?
Все знают, что в нашем организме есть эритроциты (красные клетки крови) и лейкоциты (белые клетки крови).
Но мало кто знает, что лейкоциты подразделяются ещё на:
- клетки, содержащие гранулы в цитоплазме. К ним относятся базофилы, нейтрофилы, эозинофилы;
- клетки, не содержащие гранулы в цитоплазме. Представителями этой группы являются моноциты и лимфоциты.
Таким образом, эозинофилы – разновидность лейкоцитов, которые содержат в своём составе гранулы. Что же это за гранулы? Эти гранулы находятся в цитоплазме. Поэтому при окраске клеток именно они придают эозинофилам ярко-красный цвет.
Что содержат гранулы эозинофилов? Эозинофилы содержат ряд веществ, которые и обеспечивают выполнение их функций. К ним относятся:
- главный основной белок – способствует разрушению паразитов за счёт своего токсического действия;
- катионный белок эозинофилов – также обладает токсической активностью по отношению к гельминтам, подавляет синтез антител, помогает во взаимодействии с другими клетками;
- эозинофильная пероксидаза – способствует окислению веществ, в результате которого образуются активные формы кислорода. Они в свою очередь способны подвергать клетку гибели;
- нейротоксин эозинофилов – проявляет свою активность против вирусов, активируя клетки иммунной системы на развитие воспалительной реакции.
Помимо того, что у эозинофилов есть специфические гранулы, эти клетки способны вырабатывать различные сигнальные молекулы. Они называются цитокины. Они обеспечивают функционирование цитокинов в очаге воспаления, участие в активации работы иммунной системы.
Место синтеза
Все клетки крови созревают в костном мозге. Там же из универсальной клетки-предшественницы происходит созревание эозинофилов (рисунок 1).
Рис.1. Схема созревания эозинофилов.
В кровеносное русло выходит зрелая клетка – сегментоядерный эозинофил. Если же в крови обнаруживаются молодые формы, это может свидетельствовать об избыточном разрушении эозинофилов или о поступлении большого количества сигналов в костный мозг для стимуляции образования этих клеток.
В костный мозг пришёл сигнал о необходимости синтеза эозинофилов, и уже через 4 дня эти клетки ждут своей очереди для выхода в кровоток.
Циркулируют в крови эозинофилы лишь несколько часов, после чего уходят в ткани и стоят на страже порядка. В тканях они находятся около 10 – 12 дней.
Небольшое количество эозинофилов находится в тканях, которые граничат с окружающей средой, обеспечивая защиту нашему организму.
Какие функции выполняют эозинофилы?
Ранее уже звучало то, какие эффекты могут выполнять эозинофилы за счёт специфических гранул в цитоплазме. Но для того чтобы эозинофилы были активированы, то есть для высвобождения содержимого гранул, необходим какой-либо сигнал. В основном этим сигналом служит взаимодействие активаторов с рецепторами на поверхности эозинофилов.
Активатором могут быть антитела классов Е и G, система комплемента, активированная компонентами гельминта. Помимо прямого взаимодействия с поверхностью эозинофилов тучные клетки, например, могут вырабатывать фактор хемотаксиса – соединение, которое привлекает в это место эозинофилы.
Исходя из этого, к функциям эозинофилов относятся:
- участие в аллергической реакции. При аллергической реакции из базофилов и тучных клеток выделяется гистамин, который и определяет клинические симптомы гиперчувствительности. Эозинофилы мигрируют в эту зону и способствуют расщеплению гистамина;
- токсический эффект. Это биологическое действие может проявляться по отношению к гельминтам, патогенным агентам и др;
- обладая фагоцитарной активностью, способны уничтожать патологические клетки, однако у нейтрофилов эта способность выше;
- за счёт образования активных форм кислорода проявляют своё бактерицидное действие.
Основное, что нужно запомнить – эозинофилы участвуют в аллергических реакциях и борьбе с гельминтами.
Норма содержания эозинофилов в крови у ребёнка
Как уже было упомянуто ранее, эозинофилы не находятся долгое время в кровеносном русле. Поэтому у здоровых детей не должно быть много эозинофилов.
Численные значения нормы зависят от того, каким способом проводилось определение количества клеток. В старых лабораториях проводится подсчёт лейкоцитарной формулы вручную, результат выдаётся только в относительных величинах, то есть в %.
В норме у детей до 4 лет относительное количество эозинофилов не должно превышать 7%. Старше это возраста норма такая же, как и у взрослых — не более 5%.
В современных лабораториях клетки чаще всего подсчитываются автоматически на гематологическом анализаторе, и только в исключительных случаях пересчитываются вручную. При подсчёте клеток на анализаторе результат может выдаваться в виде относительных и абсолютных величин.
Абсолютное число эозинофилов отражает их точное количество на литр крови.
Абсолютные значения эозинофилов в норме представлены в таблице.
Таблица. Норма эозинофилов в крови у детей.
| Возраст | Абсолютные количества |
| До года | 0,05 — 0,4 *10*9/л |
| Год – шест лет | 0,02 — 0,3 *10*9/л |
| Более шести лет | 0,02 — 0,5 *10*9/л |
Данные с нормальными величинами даны для ознакомления, не стоит самостоятельно заниматься расшифровкой результатом анализа!
Показания для определения уровня эозинофилов в крови
Так как эозинофилы играют важную роль при аллергических реакциях и борьбе с паразитами, то целесообразно проводить определение уровня этих клеток в крови при подозрении на эти процессы.
То есть основными показаниями для определения уровня эозинофилов в крови у ребёнка могут быть:
- после употребления какого-то продукта питания начался зуд, на коже выступил дерматит, поражение дыхательного тракта (кашель, чихание, отёк гортани) и так далее;
- головные боли, плохая усидчивость ребёнка, бессонница может говорить о наличии паразитов у него;
- низкая масса тела при повышенном аппетите может также указывать на гельминтоз;
- нарушен процесс переваривания пищи, сопровождающийся изменением стула, рвотой;
- боли в животе;
- признаки дефицита основных питательных веществ, несмотря на достаточное кормление ребёнка;
- может подниматься температура тела.
Если ваш ребёнок плачет, значит его что-то беспокоит, но он не может сказать вам об этом. Поэтому крайне важно понять, что с ним происходит и не допустить развития серьёзных осложнений.
Помимо аллергии на пищевые продукты возможно развитие гиперчувствительности на пыль, шерсть животных, пыльцу растений, даже медикаменты.
Как правильно сдавать анализ?
Чтобы результат анализа был точным и отражал действительно то, что происходит в нашем организме, надо правильно подготовиться. Тем более, что при подготовке к сдаче этого анализа нет ничего сложного.
Прежде всего, необходимо подготовиться морально и родителям, и ребёнку. Лучше всего, чтобы ребёнок не плакал, не паниковал, вёл себя спокойно. Для этого стоит родителям объяснить малышу, что будет происходить в больнице, что ничего страшного в этом нет. Может быть можно даже пообещать что-нибудь ребёнку взамен, если он будет вести себя хорошо.
Также важно не давать ребёнку бегать по коридорам больницы в ожидании своей очереди в кабинет забора крови. Физическая активность может повлиять на результаты исследования.
Также одним из самых важных правил подготовки к анализу крови является то, что необходимо сдавать натощак. Если ребёнок уже большой (старше 4 лет), тогда можно потерпеть и сдать кровь после ночного голодания. Разрешается попоить ребёнка водой.
Грудничков рекомендуется не кормить в течение 1 – 1,5 до сдачи крови.
Кровь чаще всего берётся из пальца, у совсем маленьких – из пяточки.
Немаловажным при подготовке к сдаче крови является приём назначенных медикаментов. Ряд лекарственных средств может оказывать влияние на результаты анализа. Поэтому желательно поговорить с врачом об этом. Самостоятельно ничего не предпринимайте!
Некоторые лекарства могут повлиять на уровень определяемого показателя. Так, например, Преднизолон может привести к снижению уровня эозинофилов и моноцитов крови.
Если родители правильно подготовятся к сдаче крови, то им не придётся повторно сдавать анализ, погружая своего ребёнка в стрессовую ситуацию.
Интерпретация результатов
Интерпретацией результатов должен заниматься лечащий врач, который направил вашего ребёнка на исследование крови. Если же родители самостоятельно обратились за анализом крови, то расшифровка ответа должна быть доверена специалисту. Он может находиться в том же месте, где кровь была сдана, или можно обратиться по месту жительства с уже готовым результатом анализа.
Когда эозинофилы повышены у ребенка и у взрослого такое состояние называется эозинофилия. Далее будут разобраны ситуации, когда такое возможно, почему оно возникает.
Почему повышены эозинофилы в крови у ребёнка?
Имеется ряд состояний, когда эозинофилы повышены в крови.
- В организм попал червь, то есть возник гельминтоз. В очаг поражения мигрируют эозинофилы, пытаясь избавиться от нежелательного «гостя», тем самым их количество в крови увеличивается. Наиболее частыми паразитами у детей является острица и аскарида.
- Аллергические реакции. В ответ на проникновение аллергена в организм ребёнка развивается реакция со стороны иммунитета, в ходе которой активируются различные клетки. В их число входят эозинофилы. Как уже упоминалось ранее, они способствуют расщеплению гистамина, вещества аллергии. Для того чтобы подтвердить наличие аллергической реакции, определяют уровень эозинофилов в крови. Если аллергия подтвердилась, переходят дальше к поиску того, что могло её вызвать.
- Аллергические заболевания. К этой группе относится такая патология, как бронхиальная астма, сенная лихорадка и другие. Они уже «закрепились» в организме, от них сложнее избавиться, чем от простой аллергии.
- Гиперчувствительность на лекарственные средства. Обычно она возникает сразу же после введения препарата. Такие люди потом всю жизнь должны упоминать об этом при обращении в медицинскую организацию.
- Синдром Лефлера. Эта патология связана с образованием инфильтрата в лёгких, который можно заметить при рентгеновском исследовании грудной клетки. Параллельно отмечается высокое содержание эозинофилов в крови. Однако эта патология встречается очень редко, чаще всего у лиц более старшего возраста.
- Гиперэозинофильный синдром. Такое состояние сопровождается избыточным количеством эозинофилов в крови и поражением соответствующих тканей. Никаких паразитов или аллергических заболеваний у пациента при это не обнаруживается. Что является причиной такого состояния, остаётся не изученным.
- Патология соединительной ткани. К ней относятся: васкулиты, системная красная волчанка, склеродермия и другие. Повышенный уровень эозинофилов указывает на наличие развивающегося воспалительного процесса.
- Злокачественные новообразования, например, лейкозы могут приводить к эозинофилии.
- Полицитемия сопровождается увеличением всех клеток крови, эозинофилы не стали исключением. Диагностика этого заболевания не составит труда.
- Острые бактериальные инфекции, инфекционный мононуклеоз, туберкулёз могут вызывать повышение уровня эозинофилов в крови.
Действия родителей при эозинофилии у детей
В случае обнаружения повышенного уровня эозинофилов родителям стоит обратиться к врачу. Так как это является «звоночком», что в организме ребёнка что-то происходит не так, как надо.
Если подтвердится тот факт, что у ребёнка паразит, то врач назначит препараты, способствующие выведению его из организма. Не пичкайте ребёнка лекарствами без обращения к врачу!
Если же подтвердилась аллергическая реакция, важно выявить её источник. Затем избавить ребёнка от контакта с этим аллергеном.
Вообще в любом случае обращайтесь к врачу, самостоятельность может усугубить ситуацию.
Эозинофилы являются разновидностью белых кровяных клеток, одной из главных функций которых является защита нашего организма от патогенных агентов. Так, эозинофилы защищают наш организм от гельминтов, участвуют в аллергических реакциях. Поэтому они важны при диагностике этих состояний и не только их.
Оценка статьи:
(6 4,50 из 5) Загрузка…
Эозинофилы повышены у взрослого — о чем это говорит, норма в крови, причины повышения

В данной статье мы рассмотрели, что делать, если эозинофилы повышены у взрослого,о чем это говорит. Ни один визит к врачу не обходится без стандартного общего анализа крови. Одним из критериев является подсчёт числа лейкоцитов в 1 мл крови. Повышение лейкоцитов – тревожный сигнал, указывающий на активацию иммунитета человека.
При этом увеличение каждого вида лейкоцитов указывает на группу заболеваний, отличающихся по своим проявлениям и необходимому лечению.
Что такое эозинофилы в анализе крови?
Эозинофильные лейкоциты (ЭО) – одна из разновидностей иммунных клеток. Это немногочисленная группа, циркулирующая в крови и тканях организма человека.
Первым обратил внимание на эозинофилы немецкий врач, иммунолог и бактериолог П. Эрлих. Он окрашивал мазок крови на предметном стекле различными красителями. Из всех лейкоцитов только 3-4% окрашивались красителем эозином в насыщенно розовый цвет.
Однако пик изучения пришелся на 1980 год, когда иммунологам удалось определить значение и функции эозинофилов для иммунитета человека. Основной функционал сводится к обеспечению протиаллергического и антипаразитарного иммунитета. Механизм действия реализуется за счёт способности ЭО поглощать и связывать вещества, обеспечивающие развитие аллергической реакции (например, гистамин).
Эозинофилы вырабатывают рецепторы, специфические для иммуноглобулинов Е. В норме они отсутствуют в крови человека. Однако при воздействии аллергена или проникновении паразитарных микроорганизмов, их активный синтез запускает защитные реакции иммунитета.
Образование ЭО
Как и все лейкоциты, первоначально ЭО образуются из единственной стволовой клетки в костном мозге. Контроль осуществляют вещества, синтезируемые Т-клетками тимуса и макрофагами.
Созревание (3-4 суток) ЭО происходит в костном мозге. Затем они поступают в кровь (не более 12 часов), а через стенки кровеносных сосудов – в ткани человека.
Там они выполняют свои функции, не имея возможности к делению.
Срок жизни ЭО не превышает 12 дней. Максимальная концентрация их обнаруживается в тканях лёгких, коже и слизистом эпителии органов ЖКТ.
Норма эозинофилов в крови у женщин и мужчин в таблице
Анализ на эозинофилы проводится двумя путями: по крови или мазку из носовой полости. Определить необходимый вид исследования может исключительно лечащий врач.
Мазок из носовой полости используется редко. Данный анализ обладает меньшей информативностью, чем анализ крови.
Диагностика повышенного уровня эозинофилов у взрослых и детей проводится для:
- выявления глистных и паразитарных инвазий;
- точного понимания причин повышения уровня лейкоцитов: аллергическая реакция, бактериальная, вирусная или паразитарная инфекция;
- отслеживания осложнений после приёма некоторых лекарственных средств и химиотерапии.
В результатах анализов обычно прописывается процентное содержание каждого вида лейкоцитов. При отклонении лейкоцитов от нормы, ориентация исключительно на процентное содержание клеток может стать причиной неверного диагноза. Поэтому назначается повторный тест с указанием абсолютного числа каждого вида лейкоцитов. Выражается величина в 1012/л или 109/л.
Норма эозинофилов у мужчин и женщин представлена в таблице.
| Норма эозинофилов у обоих полов | В процентном отношении от общего числа лейкоцитов | Абсолютный показатель |
| В крови (лейкоцитарная формула) | До 5 % | 0,02 — 0,5 *109/л |
| В цитологическом исследовании секрета из полости носа (риноцитограмма) | До 7 % | Не подсчитывается |
Результаты интерпретируются врачом с учётом данных о клинической картине, дополнительных анализов и информации о принимаемых пациентом лекарствах.
Принципиальной разницы в нормальных значениях для мужчин и женщин не обнаружено. Следует учитывать, что во время менструации у женщин количество клеток крови, в том числе ЭО, снижается. Для исключения недостоверных результатов назначаются повторные анализы через 1-2 недели.
Норма эозинофилов в крови у детей по возрасту
Абсолютное число ЭО у детей различного возраста отличаются от взрослых. Подобные увеличения необходимы для обеспечения иммунитета ребёнка пока организм полностью не окреп. Таблица с нормами эозинофилов для детей в мазке из носа и крови представлена ниже.
| Норма ЭО для детей | Возраст | В процентном отношении от общего числа лейкоцитов | Абсолютный показатель |
| В крови (лейкоцитарная формула) | До 1 года | До 6 % | 0,05 — 0,4 *109/л |
| От 1 до 5 лет | До 7 % | 0,02 — 0,3 *109/л | |
| В цитологическом исследовании секрета из полости носа (риноцитограмма) | До года | До 9 % | Не подсчитывается |
| От 1 до 5 лет | До 8 % |
Интерпретацию полученных данных для ребёнка проводит врач-педиатр. Самостоятельные попытки расшифровки и назначения лечения могут отрицательно сказаться на здоровье малыша, поскольку полная картина заболевания видна только врачу.
Если эозинофилы повышены у взрослого, о чем это говорит?
На уровень показателя в крови влияет время сбора биоматериала. По вечерам и рано утром количество ЭО возрастает на 15%, что является вариантом физиологической нормы. Ночью показатель может повышаться на 15-25 %.
Рекомендации к дальнейшей диагностике получает пациент, если уровень ЭО стабильно выше или на верхней границе нормы.
Повышение уровня ЭО в мазке из носа или анализе крови принято обозначать термином эозинофилия. Это патологическое состояние, причиной которого может стать широкий перечень различных заболеваний.
Читайте далее: Все о пониженных эозинофилах в крови у взрослых и детей
Основные причины повышения ЭО у взрослых по группам заболеваний
Рассмотрим причины повышения эозинофилов у взрослых пациентов по группам болезней.
Атопические заболевания
Первая группа: атопические заболевания, что указывает на генетическую предрасположенность человека к аллергической реакции. Механизм атопических болезней осуществляется за счёт реакции гиперчувствительности немедленного типа. К ним относят:
- аллергический насморк или «сенная лихорадка» – воспалительная реакция слизистой оболочки полости носа при контакте с аллергенами. Сопровождается заложенностью носа, зудом и чиханием. Может проявляться эпизодически (менее 4 дней в неделю) или приобретать хроническую форму (более 4 недель в году). Устранение контакта с раздражающим слизистую носа аллергеном значительно облегчает состояние человека;
- бронхиальную астму – хроническое аллергическое воспаление органов дыхательной системы. Сопровождается сужением просвета бронхов и гиперсекрецией густой слизи;
- сывороточное заболевание – патологическое состояние, возникающее в ответ на введение иммунных сывороток. Их основу составляют чужеродные белковые антитела животного происхождения. При этом организм человека может проявлять аллергическую реакцию на них;
- атопическую экзему – хроническое воспаление кожи. Характеризуется частыми рецидивами и сезонностью: летом заболевание проявляется значительно меньше, чем зимой;
- сезонный аллергический риноконъюнктивит – частный вид аллергической реакции человека на пыльцу.
Паразитарные заражения
Повышенные эозинофилы в крови у взрослого наблюдаются при паразитарных заражениях: аскаридами, лямблиями, описторхами, токсокарами и другими видами паразитов.
Заболевания органов пищеварительной системы
Заболевания органов ЖКТ – еще одна причина увеличения показателя. Возможные патологии: язвенная болезнь, гастрит, цирроз печени или эозинофильный гастроэнтерит.При подозрении на данные патологии пациенту показана консультация гастроэнтеролога и проведение дополнительных методов диагностики.
Заболевания крови
Отдельную группу причин повышения ЭО составляют болезни крови:
- болезнь Аддисона-Бирмера или мегабластная анемия, когда у человека нарушается нормальный процесс кроветворения на фоне недостатка витамина В12;
- лейкоз, возникающий в результате мутации стволовой клетки. Вследствие чего невозможна полноценная дифференцировка клеток крови;
- болезнь Ходжкина– злокачественная патология, причины которой не установлены;
- первичная полицитемия, приводящая к повышению концентрации эритроцитов и лейкоцитов в крови.
Прочие
Отклонение числа ЭО сопровождает также онкологические патологии, ревматические заболевания и состояние иммунодефицита, острые инфекционные заболевания (скарлатину, ветряную оспу, инфекционный мононуклеоз, туберкулез), инфаркт миокарда (повышение уровня эозинофилов является неблагоприятным диагностическим критерием), некоторые патологии легких (легочные эозинофильные пневмонии, эозинофильные плевриты, саркоидоз, эозинофильные легочные инфильтраты (болезнь Лефлера) и т.д.).
О чем это говорит,если эозинофилы повышены у ребенка?
Высокие эозинофилы в крови у ребёнка встречаются при аллергических реакциях, глистных инвазиях, заболеваниях крови или угнетении иммунитета.
Микроскопическое исследование мазка из носа имеет особое значение для детей, поскольку они в большей степени подвержены аллергическим реакциям. Важно установить точный аллерген и исключить дальнейший контакт ребёнка с ним.
Из-за слабого иммунитета малыши чаще болеют, и нередко хронический насморк списывается на простудные заболевания. Полезно будет провести дополнительное исследование мазка носа для однозначного исключения аллергического ринита. Взятие мазка безболезненно и безопасно для ребёнка.
Следует отметить, что нормальная величина ЭО в мазке из носа не может полностью исключать развитие аллергической реакции. Для однозначного исключения проводится анализ крови с определением уровня иммуноглобулинов класса Е.
Сочетанное повышение эозинофилов и моноцитов в крови у грудничка указывает на острую стадию вирусной инфекции, заболевания соединительной ткани или онкологические патологии. Проводится расширенная диагностика ребёнка.
Как понизить эозинофилы в крови?
Состояние эозинофилии корректируется лечением основного заболевания, которое его вызвало. Снижение числа ЭО в крови – один из показателей положительной динамики и улучшения состояния больного. После выздоровления проводится повторный анализ.
Методы лечения подбирает врач с учётом болезни, возраста пациента, а также наличия противопоказаний. Следует обращать внимание на минимально допустимый возраст лекарственных препаратов для детей.
Читайте далее: Расшифровка и норма мазка из носа на эозинофилы
